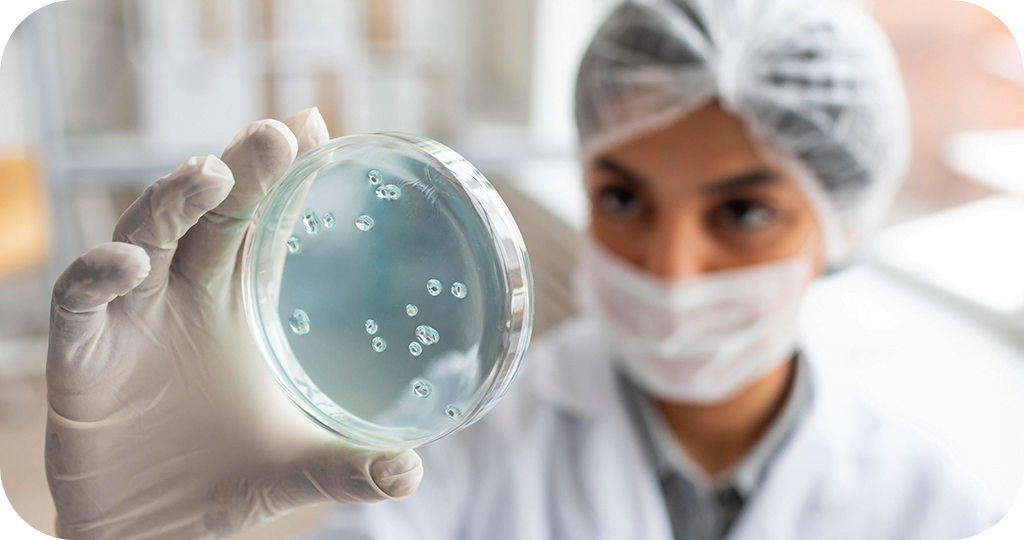

No texto a seguir abordamos os aspectos da ovodoação, técnica de alta complexidade da medicina reprodutiva que vem se tornando cada dia mais conhecida. Isto se dá pois a ovodoação ultrapassa barreiras, possibilitando que pessoas em diferentes configurações familiares possam ter filhos. Desta forma, mulheres com infertilidade, casais homoafetivos masculinos e pais solos, encontram na doação de óvulos uma chance de ter um bebê.
No texto a seguir mostramos como esse tratamento acontece e os fatores que devem ser considerados por quem decide embarcar nessa linda jornada.
Boa leitura!
O que é ovodoação?
A ovodoação é um tratamento de reprodução assistida que beneficia principalmente mulheres que enfrentam dificuldades para engravidar com seus próprios óvulos. Assim, essa técnica permite que mulheres com insuficiência ovariana severa, com falência ovariana, menopausa precoce, que passaram por tratamento oncológicos, entre outros, realizem o sonho de ter filhos.
Além disso, a ovodoação é uma alternativa valiosa para casais com alterações genéticas, produções independentes e casais homoafetivos masculinos que desejam formar suas famílias. Nestes dois últimos casos, além da doação de gametas femininos, será necessário ainda contar com a ajuda de um útero solidário.
Nesse processo, uma mulher (doadora) cede seus óvulos para que outra (receptora) os utilize na tentativa de engravidar. Isso é possível através da Fertilização In Vitro, em que a fecundação do óvulo da doadora ocorre em laboratório, utilizando o espermatozoide do parceiro da receptora. Em alguns casos, podem ser usados gametas masculinos de um banco de esperma. Desta forma, o embrião resultante da fecundação é então transferido para o útero da receptora, onde será gestado.
Prós da ovodoação
Como vimos, a ovodoação é um tratamento capaz de ultrapassar diversas barreiras, e assim, ajudar pessoas com diferentes dificuldades para engravidar. Nesse sentido, a ovodoação aumenta significativamente as chances de sucesso em tratamentos de Fertilização In Vitro (FIV), especialmente quando os óvulos doados são de mulheres jovens e saudáveis.
Também na ovodoação há a possibilidade de realizar teste genético no embrião quando indicado. No tratamento com óvulos doados, o embrião é formado em laboratório, o que permite a realização de exames para identificar alterações cromossômicas e doenças genéticas antes da transferência para o útero.
Além disso, se por um lado a doação de óvulos é muito favorável para quem recebe os gametas, por outro também beneficia quem doa. Isso porque no caso de ovodoação compartilhada, a doadora, além de dividir seus óvulos com a receptora, divide também os custos do tratamento.
Desta forma, além da satisfação pessoal de estar ajudando uma pessoa ou casal a formar sua família, ainda torna o tratamento mais acessível para ambas as partes.
Maior taxa de sucesso
As taxas de sucesso da FIV com ovodoação dependem de alguns fatores como a receptividade endometrial da receptora, e principalmente a idade da mulher ao doar os óvulos.
Portanto, na ovodoação, o importante é a idade do óvulo (doadora) e não do útero (receptora), o que aumenta as chances de gravidez. Assim, como existem critérios na escolha das doadoras, que incluem mulheres com menos de 35 anos, as chances de gestação com óvulos doados são de 50 a 60%.
Ajuda a realizar o sonho de ser mãe
A doação de óvulos é uma decisão solidária que tem como objetivo ajudar outras pessoas a terem seus filhos. Nesse sentido, existem dois tipos de ovodoação:
Ovodoação altruísta
A ovodoação voluntária se dá quando a doação dos óvulos é feita por uma mulher fértil de até 35 anos e com único objetivo de ajudar pessoas com dificuldades para ter filhos. Dessa forma, a doadora se submete a um processo de estimulação ovariana e coleta dos óvulos.
Ovodoação compartilhada
A ovodoação compartilhada ocorre quando uma mulher, que está em tratamento de reprodução assistida, divide seus óvulos coletados com outra paciente que também passa pelo processo de FIV. Ou seja, a doadora utiliza parte dos seus óvulos e doa outra parte para a mulher receptora.
Nesse caso, além dos gametas, elas compartilham também os custos do tratamento. Vale ressaltar que tudo ocorre de forma anônima e por intermédio da clínica.
Veja alguns casos quando a ovodoação é indicada:
- Mulheres com baixa reserva ovariana;
- Idade materna avançada;
- Menopausa;
- Falência Ovariana Precoce;
- Tratamentos quimioterápicos ou radioterápicos para câncer;
- Falhas frequentes na FIV com óvulos próprios;
- Abortamentos de repetição devido à baixa qualidade dos óvulos;
- Alterações genéticas ligadas ao óvulo;
- Mulheres que nasceram com ovários não funcionantes;
- Casais homoafetivos masculinos, com ajuda de útero de substituição;
- Produção independente com ajuda de e útero solidário;
- Doenças Genéticas.
Contribuição para a ciência e outras famílias
A doação de óvulos representa um grande avanço da ciência, sendo um pilar importante na pesquisa e desenvolvimento de novas técnicas de reprodução assistida. Assim, o aprimoramento da medicina reprodutiva acarreta melhora das taxas de sucesso das FIVs, e contribui para a descoberta de novos tratamentos eficazes e seguros.
Hoje a ovodoação já ajuda milhares de pessoas impossibilitadas de gerar um embrião com seus gametas a formarem suas famílias. Por conseguinte, ainda que uma mulher não consiga engravidar com seus óvulos, ela pode gestar seu filho e ter a vivência da gravidez.
Portanto, a ovodoação é um passo gigante no leque de possibilidades da medicina reprodutiva na busca pela realização do sonho de ter filhos.
Contras da ovodoação
Como já foi dito, a ovodoação é uma alternativa promissora para mulheres que enfrentam dificuldades para engravidar com seus próprios gametas. Além disso, a técnica permite também que casais homoafetivos masculinos e pais solos tenham filhos.
Aspectos emocionais e psicológicos
Outro aspecto a se considerar é um possível impacto emocional, tanto para a doadora quanto para a receptora dos óvulos.
Nesse sentido, quem doa seus óvulos pode ter um sentimento de perda ou arrependimento em ter doado seus gametas que carregam sua genética.
Já para a receptora, pode surgir a preocupação com a falta de vínculo genético com o futuro filho, o que gera inseguranças e dúvidas sobre a maternidade. Entretanto, estudos demonstram que a epigenética e o ambiente de criação têm papéis fundamentais na herança, nos comportamentos e nos vínculos que se formam.
Desta maneira, a epigenética pode interferir na forma como o DNA vai funcionar, agindo na expressão dos genes. Portanto, apesar do embrião carregar a herança genética do óvulo doado e do espermatozoide usado na Fertilização in Vitro (FIV), ele pode sofrer influências além da genética.
Inclusive o ambiente intrauterino pode promover essas modificações epigenéticas. Com isso, mães que passaram por ovodoação tendem a deixar marcas únicas e duradouras no bebê que gestam.
Essas mudanças podem se manifestar de diversas formas, como no comportamento social, no QI e até mesmo no padrão alimentar dos indivíduos.
Riscos e complicações

É importante esclarecer que a ovodoação, assim como o congelamento de óvulos e demais tratamentos de reprodução humana, é segura quando realizada por profissionais qualificados. Entretanto, alguns procedimentos médicos podem causar efeitos colaterais ou riscos associados aos próprios tratamentos.
Neste caso, para doadora, que passa por estimulação ovariana através de hormônios, é comum haver inchaço abdominal, alterações de humor e dores de cabeça. Além disso, embora rara, outra complicação decorrente dos indutores de ovulação usados para aumentar os números óvulos é a síndrome do hiperestimulação ovariana (SHO).
Ainda que minimamente também podem ocorrer infecções, sangramentos ou complicações anestésica decorrente da coleta dos óvulos.
Já para as receptoras, os possíveis riscos são os mesmos de qualquer gestação como aborto espontâneo, hipertensão, diabetes gestacional, parto prematuro, entre outros.
Aspectos éticos e legais
Quando falamos sobre ovodoação é comum surgirem dúvidas sobre questões éticas e legais que envolvem essa técnica de reprodução assistida. Neste sentido, é importante saber que em muitos países a doação de óvulos segue regulamentações rígidas que definem os limites deste tratamento.
No Brasil, a ovodoação é protegida por normativas como a Resolução – RDC N° 771/2022 da Diretoria Colegiada da Agência Nacional de Vigilância Sanitária (Anvisa).
Além disso, as regras tratamentos da reprodução humana também estão definidas na Resolução nº 2.320/22, do Conselho Federal de Medicina (CFM), publicada em 2022.
Conheça as regras para ovodoação no Brasil:
- A doação não poderá ter caráter lucrativo ou comercial;
- Os doadores não devem conhecer a identidade dos receptores e vice-versa, a não ser nos casos de doações de parentes até 4° grau de parentesco, contanto que não ocorra consanguinidade;
- A idade limite para a doação de gametas é de 37 anos para a mulher e de 45 anos para o homem;
- No caso das doações anônimas, mantém-se, obrigatoriamente, sigilo sobre a identidade dos doadores de gametas e embriões, bem como dos receptores. Em situações especiais como motivação médica, informações sobre os doadores podem ser fornecidas exclusivamente para médicos, resguardando-se a identidade civil do(a) doador(a);
- A escolha das doadoras de oócitos é de responsabilidade do médico assistente. Dentro do possível, deverá garantir que a doadora tenha a maior semelhança fenotípica com a receptora;
- Permite-se a doação voluntária de gametas, bem como a doação compartilhada de oócitos em RA, quando a doadora e receptora participam de tratamento de medicina reprodutiva. Desta forma, compartilham tanto do material biológico quanto dos custos financeiros que envolvem os tratamentos, sendo que a doadora tem preferência sobre o material biológico;
- Doação entre parentes.
Processo de ovodoação

A ovodoação é um tratamento que envolve várias etapas. Assim, compreende estímulo ovariano e punção de gametas da doadora, coleta dos espermatozoides (sêmen), fecundação in vitro, preparo do útero da receptora para transferência do embrião.
Para que o tratamento tenha sucesso, é preciso que cada etapa seja acompanhada de perto por especialistas em reprodução humana.
Como funciona a ovodoação?
Etapas da ovodoação:
- Estimulação ovariana: essa é a primeira etapa do processo e consiste em administração medicamentosa, por cerca de 10 dias, para estimular que os folículos se desenvolvam. Essa quantidade pode variar muito de mulher para mulher, de acordo com a sua reserva ovariana;
- Controle da ovulação por ultrassonografia: durante a estimulação acompanha-se, o crescimento dos folículos por ultrassonografia. Quando atingem um certo tamanho, administra-se na doadora o hormônio hCG, ou análogo do GnRH. Sua função é provocar o amadurecimento dos óvulos de dentro dos folículos;
- Punção folicular: cerca de 36 horas após a administração do hCG, ou análogo do GnRH, acontece a aspiração do conteúdo existente dentro de cada folículo, no qual ficam os óvulos. Esse procedimento é guiado por ultrassom e com uma agulha acoplada no aparelho ocorre a aspiração de todos os folículos que se desenvolvem durante a estimulação ovariana de forma indolor, pois a paciente é anestesiada;
- Congelamento dos óvulos: após a coleta, pode-se manter os óvulos podem ficar criopreservados por tempo indeterminado.
No caso de ovodoação compartilhada, quando já existe uma receptora selecionada, no momento em que se coleta os óvulos da doadora, coleta-se também os espermatozoides do marido da receptora. Assim, os embriologistas podem começar o processo de Fertilização In Vitro, unindo os dois gametas em laboratório para formar embriões.
Após alguns dias em cultivo, ocorre a transferência dos embriões para o útero da futura mãe. O mesmo pode acontecer utilizando espermatozoides doados.
A paciente receptora passa pelo preparo do endométrio, através de administração medicamentosa, realizando controle por meio de ultrassonografias.
Após a avaliação do exame de imagem, o médico poderá realizar a transferência do embrião ao útero.
Considerações Finais
A ovodoação é um tratamento de reprodução assistida que ajuda mulheres com dificuldades para engravidar com seus próprios óvulos. Assim, beneficia especialmente aquelas com falência ovariana, menopausa precoce, ou que passaram por tratamentos oncológicos. Além disso, também é uma solução para casais com alterações genéticas, produções independentes e casais homoafetivos masculinos que desejam filhos.
O tratamento envolve uma mulher doadora que cede seus óvulos para outra mulher receptora. Desta forma, a fertilização ocorre em laboratório usando espermatozoide do parceiro da receptora ou de banco de sêmen. Depois, o embrião resultante da Fertilização in vitro (FIV) é transferido ao útero da receptora onde será gestado.
Nesse sentido, um dos principais benefícios da ovodoação é que aumenta significativamente as chances de sucesso em tratamentos de FIV, especialmente com óvulos de mulheres jovens e saudáveis. Nestes casos, as taxas de gravidez chegam a 50-60%. Por outro lado, os custos elevados e possíveis impactos emocionais, tanto para doadoras quanto para receptoras, são alguns “contras” da doação de óvulos.
De qualquer forma, seja altruísta ou compartilhada, a ovodoação tem ajudado a formar milhares de novas famílias ao redor do mundo.
Após a leitura, recomendamos que você consulte nosso guia completo sobre ovodoação para mais informações detalhadas e apoio profissional.






